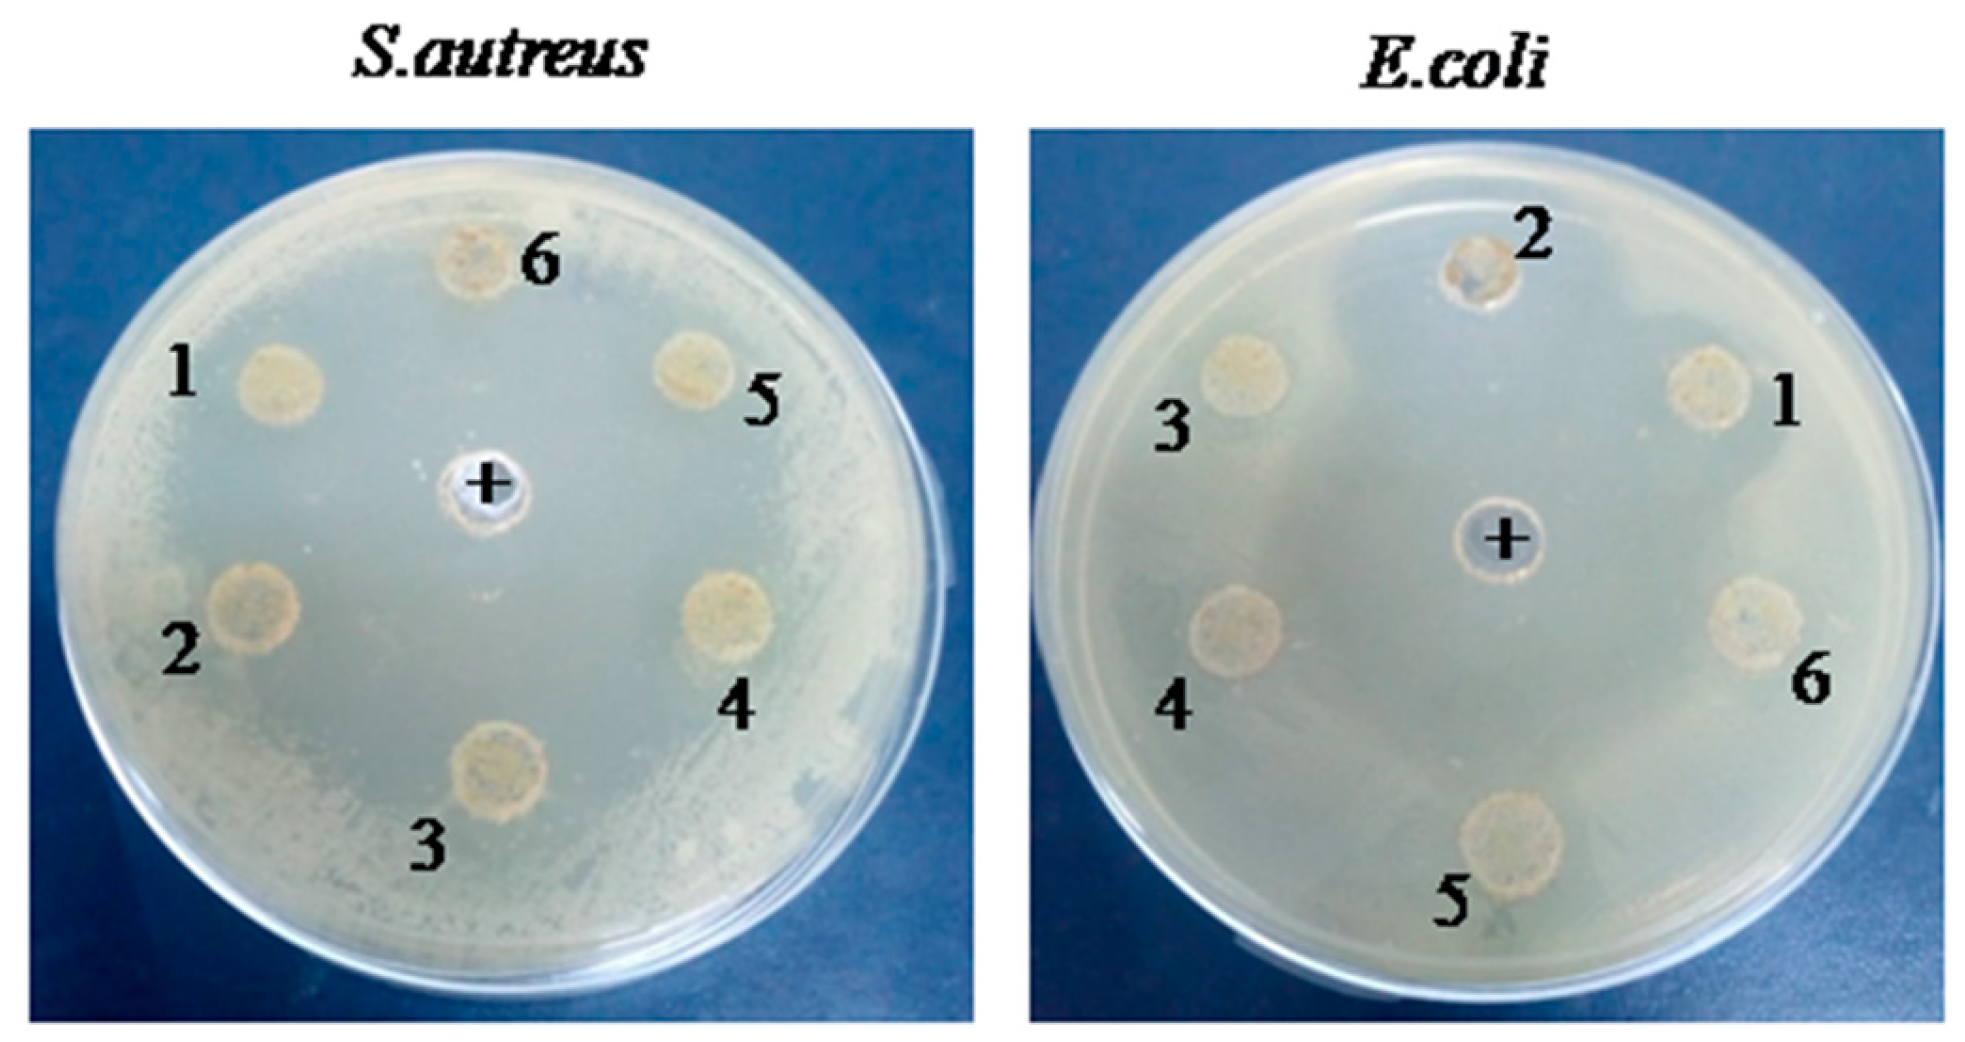
Pharmaceuticals 17 00545 g001

Antibacterial, Anti-Biofilm, and Anti-Inflammatory Properties of Gelatin–Chitosan–Moringa-Biopolymer-Based Wound Dressings towards Staphylococcus aureus and Escherichia coli
Abstract
1. Introduction
2. Results
2.1. Rheological Properties
2.2. Antibacterial Activities
2.3. Anti-Biofilm Activity
2.4. Modulation of Bacteria Motility
2.5. Antioxidant Activities
2.5.1. DPPH Assay
2.5.2. Ferrous Chelating Activity
2.6. DNA Damage Protective Effect Assay
2.7. Anti-Inflammatory Activity
2.8. Blood Haemolysis Test
3. Discussion
4. Materials and Methods
4.1. Chemical and Reagent
4.2. Extraction of Gelatin
4.3. Polymer (G–CH–M) Construction
4.4. Rheological Properties
4.4.1. Density
4.4.2. Porosity
4.4.3. Swelling Capacity
4.5. Antibacterial Activity of G–CH–M Biopolymer
4.5.1. Agar Diffusion Assay
4.5.2. Liquid Medium Microdilution Assay
4.6. Crystal Violet Biofilm Assay
4.7. Motility Assay
4.8. Antioxidant Activities
4.8.1. DPPH Radical-Scavenging Activity
4.8.2. Ferrous Chelating Activity
4.9. DNA Damage Protective Effect Assay
4.10. Blood Haemolysis
4.11. Anti-Inflammatory Activity
4.12. Statistical Analysis
5. Conclusions
Author Contributions
Funding
Institutional Review Board Statement
Informed Consent Statement
Data Availability Statement
Acknowledgments
Conflicts of Interest
Abbreviations
References
- Arfat, Y.A.; Benjakul, S.; Prodpran, T.; Sumpavapol, P.; Songtipya, P. Properties and antimicrobial activity of fish protein isolate/fish skin gelatin film containing basil leaf essential oil and zinc oxide nanoparticles. Food Hydrocoll. 2014, 41, 265–273. [Google Scholar] [CrossRef]
- Kuijpers, A.J.; Van Wachem, P.B.; van Luyn, M.J.; Plantinga, J.A.; Engbers, G.H.; Krijgsveld, J.; Zaat, S.A.; Dankert, J.; Feijen, J. In vivo compatibility and degradation of cross linked gelatin gels incorporated in knitted Dacron. J. Biomed. Mater. Res. 2000, 51, 136–145. [Google Scholar] [CrossRef]
- Gómez-Guillén, M.C.; Giménez, B.; López-Caballero, M.A.; Montero, M.P. Functional and bioactive properties of collagen and gelatin from alternative sources: A review. Food Hydrocoll. 2011, 25, 1813–1827. [Google Scholar] [CrossRef]
- Al-Hassan, A.A. Gelatin from camel skins: Extraction and characterizations. Food Hydrocoll. 2020, 101, 105457. [Google Scholar] [CrossRef]
- Gorczyca, G.; Tylingo, R.; Szweda, P.; Augustin, E.; Sadowska, M.; Milewski, S. Preparation and characterization of genipin cross-linked porous chitosan–collagen–gelatin scaffolds using chitosan–CO2 solution. Carbohydr. Polym. 2014, 102, 901–911. [Google Scholar] [CrossRef]
- Liu, X.F.; Guan, Y.L.; Yang, D.Z.; Li, Z.; Yao, K.D. Antibacterial action of chitosan and carboxymethylated chitosan. J. Appl. Polym. Sci. 2001, 79, 1324–1335. [Google Scholar]
- Croisier, F.; Jérôme, C. Chitosan-based biomaterials for tissue engineering. Eur. Polym. J. 2013, 49, 780–792. [Google Scholar] [CrossRef]
- Matica, M.A.; Aachmann, F.L.; Tøndervik, A.; Sletta, H.; Ostafe, V. Chitosan as a wound dressing starting material: Antimicrobial properties and mode of action. Int. J. Mol. Sci. 2019, 20, 5889. [Google Scholar] [CrossRef]
- Suganya, S.; Senthil Ram, T.; Lakshmi, B.; Giridev, V. Herbal drug incorporated antibacterial nanofibrous mat fabricated by electrospinning: An excellent matrix for wound dressings. J. Appl. Polym. Sci. 2011, 121, 2893–2899. [Google Scholar] [CrossRef]
- Shan, Y.-H.; Peng, L.-H.; Liu, X.; Chen, X.; Xiong, J.; Gao, J.-Q. Silk fibroin/gelatin electrospun nanofibrous dressing functionalized with astragaloside IV induces healing and anti-scar effects on burn wound. Inter. J. Pharm. 2015, 479, 291–301. [Google Scholar] [CrossRef]
- Mbikay, M. Therapeutic potential of Moringa oleifera leaves in chronic hyperglycemia and dyslipidemia: A review. Front. Pharmacol. 2012, 3, 24. [Google Scholar] [CrossRef]
- Gothai, S.; Arulselvan, P.; Tan, W.S.; Fakurazi, S. Wound healing properties of ethyl acetate fraction of Moringa oleifera in normal human dermal fbroblasts. J. Intercult. Ethnopharmacol. 2016, 5, 1–6. [Google Scholar] [CrossRef]
- Muhammad, A.A.; Pauzi, N.A.; Arulselvan, P.; Abas, F.; Fakurazi, S. In vitro wound healing potential and identifcation of bioactive compounds from Moringa oleifera Lam. BioMed Res. Int. 2013, 2013, 974580. [Google Scholar] [CrossRef]
- Saini, R.K.; Sivanesan, I.; Keum, Y.S. Phytochemicals of Moringa oleifera: A review of their nutritional, therapeutic and industrial significance. 3 Biotech 2016, 6, 203. [Google Scholar] [CrossRef]
- Ma, Z.F.; Ahmad, J.; Zhang, H.; Khan, I.; Muhammad, S. Evaluation of phytochemical and medicinal properties of Moringa (Moringa oleifera) as a potential functional food. S. Afr. J. Bot. 2020, 129, 40–46. [Google Scholar] [CrossRef]
- Rubio-Elizalde, I.; Bernáldez-Sarabia, J.; Moreno-Ulloa, A.; Vilanova, C.; Juárez, P.; Licea- Navarro, A.; Castro-Ceseña, A.B. Scaffolds based on alginate-PEG methyl ether methacrylate-Moringa oleifera-Aloe vera for wound healing applications. Carbohydr. Polym. 2019, 206, 455–467. [Google Scholar] [CrossRef]
- Chin, C.Y.; Ng, P.Y.; Ng, S.F. Moringa oleifera standardised aqueous leaf extractloaded hydrocolloid film dressing: In vivo dermal safety and wound healing evaluation in STZ/HFD diabetic rat model. Drug Deliv. Transl. Res. 2019, 9, 453–468. [Google Scholar] [CrossRef]
- Singh, B.; Kumar, A. Graft and crosslinked polymerization of polysaccharide gum to form hydrogel wound dressings for drug delivery applications. Carbohydr. Res. 2020, 489, 107949. [Google Scholar] [CrossRef]
- ASTM International. Standard Practice for Assessment of Hemolytic Properties of Materials. Available online: https://standards.globalspec.com/std/3864067/astm-f756-17 (accessed on 20 December 2023).
- Thaya, R.; Vaseeharan, B.; Sivakamavalli, J.; Iswarya, A.; Govindarajan, M.; Alharbi, N.S.; Kadaikunnan, S.; Al-Anbr, M.N.; Khaled, J.M.; Benelli, G. Synthesis of chitosan-alginate microspheres with high antimicrobial and antibiofilm activity against multi-drug resistant microbial pathogens. Microb. Pathog. 2018, 114, 17–24. [Google Scholar] [CrossRef]
- Divya, M.; Vaseeharan, B.; Abinaya, M.; Vijayakumar, S.; Govindarajan, M.; Alharbi, N.S.; Kadaikunnan, S.; Khaled, J.M.; Benelli, G. Biopolymer gelatin-coated zinc oxide nanoparticles showed high antibacterial, antibiofilm and anti-angiogenic activity. J. Photochem. Photobiol. B Biol. 2018, 178, 211–218. [Google Scholar] [CrossRef]
- Bukar, A.; Uba, A.; Oyeyi, T. Antimicrobial profile of Moringa oleifera Lam. extracts against some food-borne microorganisms. Bayero. J. Pure Appl. Sci. 2010, 3, 43–48. [Google Scholar] [CrossRef]
- Ajose, D.J.; Oluwarinde, B.O.; Abolarinwa, T.O.; Fri, J.; Montso, K.P.; Fayemi, O.E.; Aremu, A.O.; Ateba, C.N. Combating bovine mastitis in the dairy sector in an era of antimicrobial resistance: Ethno-veterinary medicinal option as a viable alternative approach. Front. Vet. Sci. 2022, 9, 800322. [Google Scholar] [CrossRef]
- Butler, M.T.; Wang, Q.F.; Harshey, R.M. Cell density and mobility protect swarming bacteria against antibiotics. Proc. Natl. Acad. Sci. USA 2010, 107, 3776–3781. [Google Scholar] [CrossRef]
- O’Toole, G.; Kaplan, H.B.; Kolter, R. Biofilm formation as microbial development. Annu. Rev. Microbiol. 2000, 54, 49–79. [Google Scholar] [CrossRef]
- Vaseeharan, B.; Sivakamavalli, J.; Thaya, R. Synthesis and characterization of chitosan-ZnO composite and its antibiofilm activity against aquatic bacteria. J. Compos. Mater. 2015, 49, 177–184. [Google Scholar] [CrossRef]
- Siddhuraju, P.; Becker, K. Antioxidant properties of various solvent extracts of total phenolic constituents from three different agroclimatic origins of drumstick tree (Moringa oleifera Lam.) leaves. J. Agric. Food Chem. 2003, 51, 2144–2155. [Google Scholar] [CrossRef]
- Shibata, H.; Sakamoto, Y.; OKA, M.; KONO, Y. Natural antioxidant, chlorogenic acid, protects against DNA breakage caused by monochloramine. Biosci. Biotechnol. Biochem. 1999, 63, 1295–1297. [Google Scholar] [CrossRef]
- Alhakmani, F.; Kumar, S.; Khan, S.A. Estimation of total phenolic content, in-vitro antioxidant and anti-inflammatory activity of flowers of Moringa oleifera. Asian Pac. J. Trop. Biomed. 2013, 3, 623–627. [Google Scholar] [CrossRef]
- Fard, M.T.; Arulselvan, P.; Karthivashan, G.; Adam, S.K.; Fakurazi, S. Bioactive extract from Moringa oleifera inhibits the pro-inflammatory mediators in lipopolysaccharide stimulated macrophages. Pharmacogn. Mag. 2015, 11, S556. [Google Scholar]
- Bessalah, S.; Jebahi, S.; Faraz, A.; Raoufi, A.; Tırınk, C.; Dridi, W.; Mohamed Hammadi, A.W. Effect of gamma radiation on novel gelatin extracted from camel skin for pharmaceutical application. Pak. J. Zool. 2023, 55, 819. [Google Scholar] [CrossRef]
- Rahman, M.M.; Pervez, S.; Nesa, B.; Khan, M.A. Preparation and characterization of porous scaffold composite films by blending chitosan and gelatin solutions for skin tissue engineering. Polym. Int. 2013, 62, 79–86. [Google Scholar] [CrossRef]
- Raoufi, Z.; Abdollahi, S. Development of Gelatin/Shekar tighal/Persian gum-based films reinforced with Anghozeh oil for potential wound dressing applications. Polym. Bull. 2023, 2023, 1–20. [Google Scholar] [CrossRef]
- Rajasree, S.R.; Gobalakrishnan, M.; Aranganathan, L.; Karthih, M.G. Fabrication and characterization of chitosan based collagen/gelatin composite scaffolds from big eye snapper Priacanthus hamrur skin for antimicrobial and anti oxidant applications. Mater. Sci. Eng. C 2020, 107, 110270. [Google Scholar] [CrossRef]
- Wang, H.M.; Chou, Y.T.; Wen, Z.H.; Wang, Z.R.; Chen, C.H.; Ho, M.L. Novel biodegradable porous scaffold applied to skin regeneration. PLoS ONE 2013, 8, e56330. [Google Scholar]
- Wang, S.; Zheng, F.; Huang, Y.; Fang, Y.; Shen, M.; Zhu, M.; Shi, X. Encapsulation of amoxicillin within laponite-doped poly (lactic-co-glycolic acid) nanofibers: Preparation, characterization, and antibacterial activity. ACS Appl. Mater. Inter. 2012, 4, 6393–6401. [Google Scholar] [CrossRef]
- O’Toole, G.A.; Kolter, R. Flagellar and twitching motility are necessary for Pseudomonas aeruginosa biofilm development. Mol. Microbiol. 1998, 30, 295–304. [Google Scholar] [CrossRef]
- Lee, J.H.; Cho, H.S.; Joo, S.W.; Chandra Regmi, S.; Kim, J.A.; Ryu, C.M.; Ryu, S.Y.; Cho, M.H.; Lee, J. Diverse plant extracts and trans-resveratrol inhibit biofilm formation and swarming of Escherichia coli O157: H7. Biofouling 2013, 29, 1189–1203. [Google Scholar] [CrossRef]
- Bersuder, P.; Hole, M.; Smith, G. Antioxidants from a heated histidine-glucose model system. I: Investigation of the antioxidant role of histidine and isolation of antioxidants by high-performance liquid chromatography. J. Am. Oil Chem. Soc. 1998, 75, 181–187. [Google Scholar]
- Hus, B.; Coupar, I.M.; Ng, K. Antioxidant activity of hot water extract from the fruit of the Doum palm Hyphaene thebaica. Food Chem. 2006, 98, 317–328. [Google Scholar]
- Lee, J.C.; Kim, H.R.; Kim, J.; Jang, Y.S. Antioxidant property of an ethanol extract of the stem of Opuntia ficus-indica var. Saboten. J. Agric. Food Chem. 2002, 50, 6490–6496. [Google Scholar] [CrossRef]

Disclaimer/Publisher’s Note: The statements, opinions and data contained in all publications are solely those of the individual author(s) and contributor(s) and not of MDPI and/or the editor(s). MDPI and/or the editor(s) disclaim responsibility for any injury to people or property resulting from any ideas, methods, instructions or products referred to in the content. |
© 2024 by the authors. Licensee MDPI, Basel, Switzerland. This article is an open access article distributed under the terms and conditions of the Creative Commons Attribution (CC BY) license (https://creativecommons.org/licenses/by/4.0/).
Share and Cite
Bessalah, S.; Faraz, A.; Dbara, M.; Khorcheni, T.; Hammadi, M.; Ajose, D.J.; Saeed, S.I. Antibacterial, Anti-Biofilm, and Anti-Inflammatory Properties of Gelatin–Chitosan–Moringa-Biopolymer-Based Wound Dressings towards Staphylococcus aureus and Escherichia coli. Pharmaceuticals 2024, 17, 545. https://doi.org/10.3390/ph17050545
Bessalah S, Faraz A, Dbara M, Khorcheni T, Hammadi M, Ajose DJ, Saeed SI. Antibacterial, Anti-Biofilm, and Anti-Inflammatory Properties of Gelatin–Chitosan–Moringa-Biopolymer-Based Wound Dressings towards Staphylococcus aureus and Escherichia coli. Pharmaceuticals. 2024; 17(5):545. https://doi.org/10.3390/ph17050545
Chicago/Turabian StyleBessalah, Salma, Asim Faraz, Mohamed Dbara, Touhami Khorcheni, Mohamed Hammadi, Daniel Jesuwenu Ajose, and Shamsaldeen Ibrahim Saeed. 2024. "Antibacterial, Anti-Biofilm, and Anti-Inflammatory Properties of Gelatin–Chitosan–Moringa-Biopolymer-Based Wound Dressings towards Staphylococcus aureus and Escherichia coli" Pharmaceuticals 17, no. 5: 545. https://doi.org/10.3390/ph17050545
APA StyleBessalah, S., Faraz, A., Dbara, M., Khorcheni, T., Hammadi, M., Ajose, D. J., & Saeed, S. I. (2024). Antibacterial, Anti-Biofilm, and Anti-Inflammatory Properties of Gelatin–Chitosan–Moringa-Biopolymer-Based Wound Dressings towards Staphylococcus aureus and Escherichia coli. Pharmaceuticals, 17(5), 545. https://doi.org/10.3390/ph17050545

